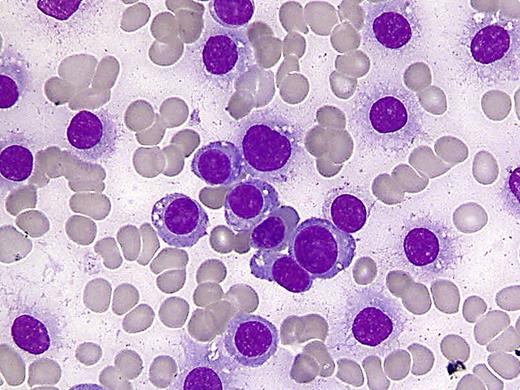
A 35-year-old multigravida with a 24-week pregnancy presented with generalized weakness and altered sensorium for 2 weeks. Physical examination revealed pallor and an enlarged uterus corresponding to gestational age. Complete blood counts showed hemoglobin 81 g/L, white cell count 259 × 109/L, and platelet count 71 × 109/L. A review of peripheral blood film (see figure) displayed 90% plasma cells, a bluish background, rouleaux, occasional nucleated red blood, and low platelets. A bone marrow examination showed replacement by plasma cells. Other laboratory tests showed a normal creatinine, uric acid 9.18 mg/dL, lactate dehydrogenase 913U/L, serum calcium (corrected for albumin) 14 mg/dL, and an IgA monoclonal gammopathy. Fetal sonographic evaluation indicated a single living fetus. For medical reasons, her pregnancy was terminated. Treatment was started with hydration, bisphosphonate, and allopurinol, which effectively improved her altered sensorium. There was hematologic improvement after chemotherapy; however, 3 months later her clinical condition deteriorated with the development of renal failure and recurrence of marked elevations of plasma cells. She was treated for her renal failure and further courses of chemotherapy were given. Patient is still alive and stable 6 months after the diagnosis. / Only a limited number of cases of myeloma during pregnancy have been described. In addition, the appearance of extraordinary numbers of circulating plasma cells is most unusual in plasma cell leukemia.

A 35-year-old multigravida with a 24-week pregnancy presented with generalized weakness and altered sensorium for 2 weeks. Physical examination revealed pallor and an enlarged uterus corresponding to gestational age. Complete blood counts showed hemoglobin 81 g/L, white cell count 259 × 109/L, and platelet count 71 × 109/L. A review of peripheral blood film (see figure) displayed 90% plasma cells, a bluish background, rouleaux, occasional nucleated red blood, and low platelets. A bone marrow examination showed replacement by plasma cells. Other laboratory tests showed a normal creatinine, uric acid 9.18 mg/dL, lactate dehydrogenase 913U/L, serum calcium (corrected for albumin) 14 mg/dL, and an IgA monoclonal gammopathy. Fetal sonographic evaluation indicated a single living fetus. For medical reasons, her pregnancy was terminated. Treatment was started with hydration, bisphosphonate, and allopurinol, which effectively improved her altered sensorium. There was hematologic improvement after chemotherapy; however, 3 months later her clinical condition deteriorated with the development of renal failure and recurrence of marked elevations of plasma cells. She was treated for her renal failure and further courses of chemotherapy were given. Patient is still alive and stable 6 months after the diagnosis.
Only a limited number of cases of myeloma during pregnancy have been described. In addition, the appearance of extraordinary numbers of circulating plasma cells is most unusual in plasma cell leukemia.
A 35-year-old multigravida with a 24-week pregnancy presented with generalized weakness and altered sensorium for 2 weeks. Physical examination revealed pallor and an enlarged uterus corresponding to gestational age. Complete blood counts showed hemoglobin 81 g/L, white cell count 259 × 109/L, and platelet count 71 × 109/L. A review of peripheral blood film (see figure) displayed 90% plasma cells, a bluish background, rouleaux, occasional nucleated red blood, and low platelets. A bone marrow examination showed replacement by plasma cells. Other laboratory tests showed a normal creatinine, uric acid 9.18 mg/dL, lactate dehydrogenase 913U/L, serum calcium (corrected for albumin) 14 mg/dL, and an IgA monoclonal gammopathy. Fetal sonographic evaluation indicated a single living fetus. For medical reasons, her pregnancy was terminated. Treatment was started with hydration, bisphosphonate, and allopurinol, which effectively improved her altered sensorium. There was hematologic improvement after chemotherapy; however, 3 months later her clinical condition deteriorated with the development of renal failure and recurrence of marked elevations of plasma cells. She was treated for her renal failure and further courses of chemotherapy were given. Patient is still alive and stable 6 months after the diagnosis.
Only a limited number of cases of myeloma during pregnancy have been described. In addition, the appearance of extraordinary numbers of circulating plasma cells is most unusual in plasma cell leukemia.
For additional images, visit the ASH IMAGE BANK, a reference and teaching tool that is continually updated with new atlas and case study images. For more information visit http://imagebank.hematology.org.